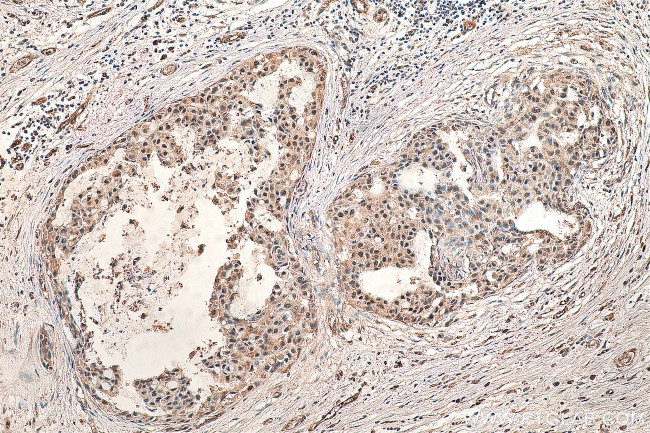
ESRP2 Antibody in Immunohistochemistry (Paraffin) (IHC (P))

Search
Proteintech
ESRP2 Polyclonal Antibody
{{$productOrderCtrl.translations['antibody.pdp.commerceCard.promotion.promotions']}}
{{$productOrderCtrl.translations['antibody.pdp.commerceCard.promotion.viewpromo']}}
{{$productOrderCtrl.translations['antibody.pdp.commerceCard.promotion.promocode']}}: {{promo.promoCode}} {{promo.promoTitle}} {{promo.promoDescription}}. {{$productOrderCtrl.translations['antibody.pdp.commerceCard.promotion.learnmore']}}
产品信息
23117-1-AP
种属反应
宿主/亚型
分类
类型
抗原
偶联物
形式
浓度
规格
纯化类型
保存液
内含物
保存条件
运输条件
产品详细信息
Immunogen sequence: TYTTFQATP TLIPTETAAL YPSSALLPAA RVPAAPTPVA YYPGPATQLY LNYTAYYPSP PVSPTTVGYL TTPTAALASA PTSVLSQSGA LVRMQGVPYT AGMKDLLSVF QAYQLPADDY TSLMPVGDPP RTVLQAPKEW VCL (585-727 aa encoded by BC030146)
靶标信息
RBM35A, also known as ESRP2, is a mRNA splicing factor that with its related protein RBM35A (ESRP1) are coordinators of an epithelial cell-type-specific splicing program. Both RBM35B and RBM35A are involved in posttranscriptional regulation of a number of genes such as FGFR2, CD44, CTNND1, and ENAH by exerting a differential effect on protein translation via 5' UTRs of mRNAs, suggesting that these proteins are global regulators of an epithelial regulatory network. Loss of this global ESRP-regulated epithelial splicing program induces the phenotypic changes in cell morphology that are observed during the epithelial-mesenchymal transition.
仅用于科研。不用于诊断过程。未经明确授权不得转售。
生物信息学
蛋白别名: Epithelial splicing regulatory protein 2; RNA binding motif protein 35A; RNA binding motif protein 35b; RNA-binding motif protein 35B; RNA-binding protein 35B; unnamed protein product
基因别名: 9530027K23Rik; ESRP2; PP7059; RBM35B
UniProt ID: (Human) Q9H6T0, (Mouse) Q8K0G8
Entrez Gene ID: (Human) 80004, (Mouse) 77411